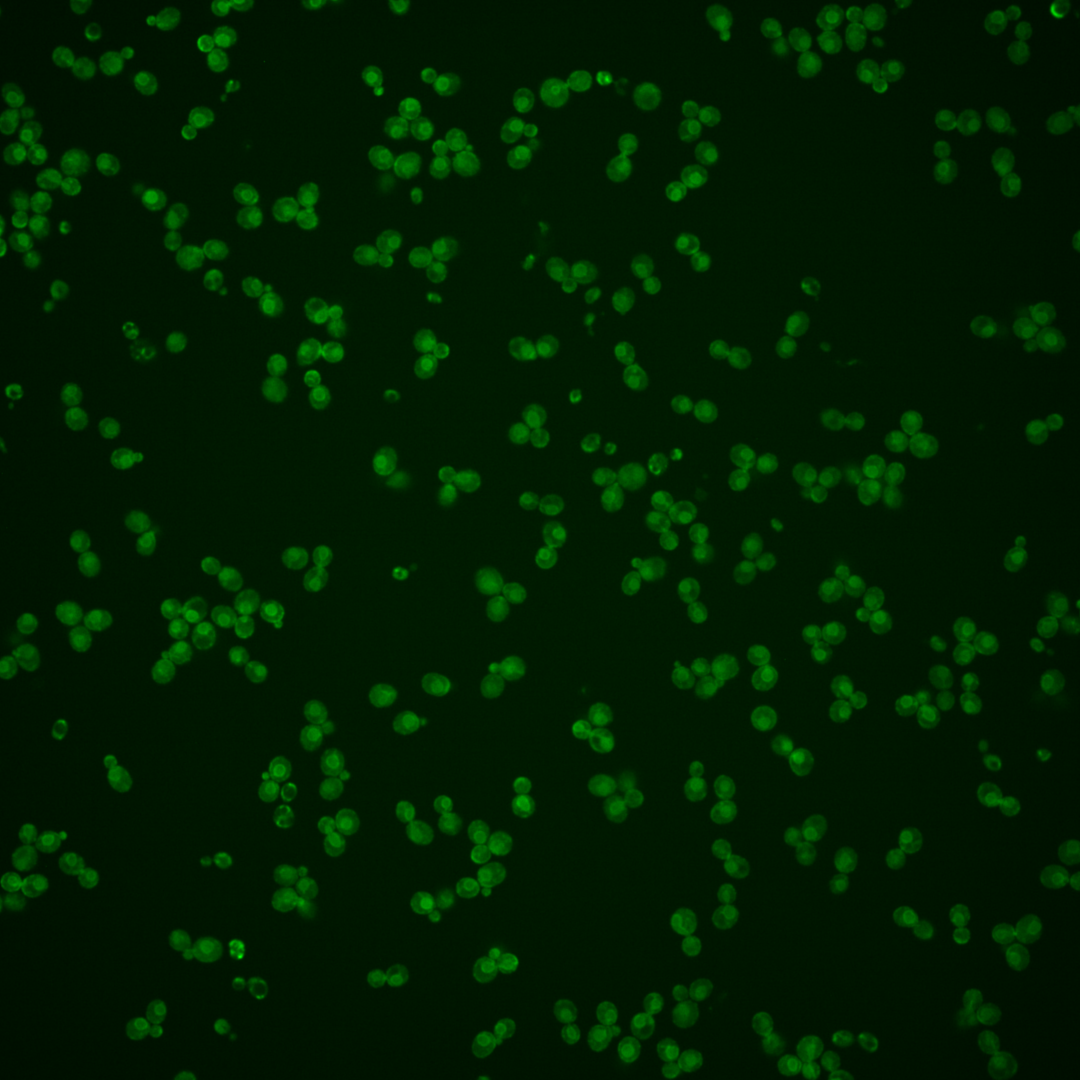
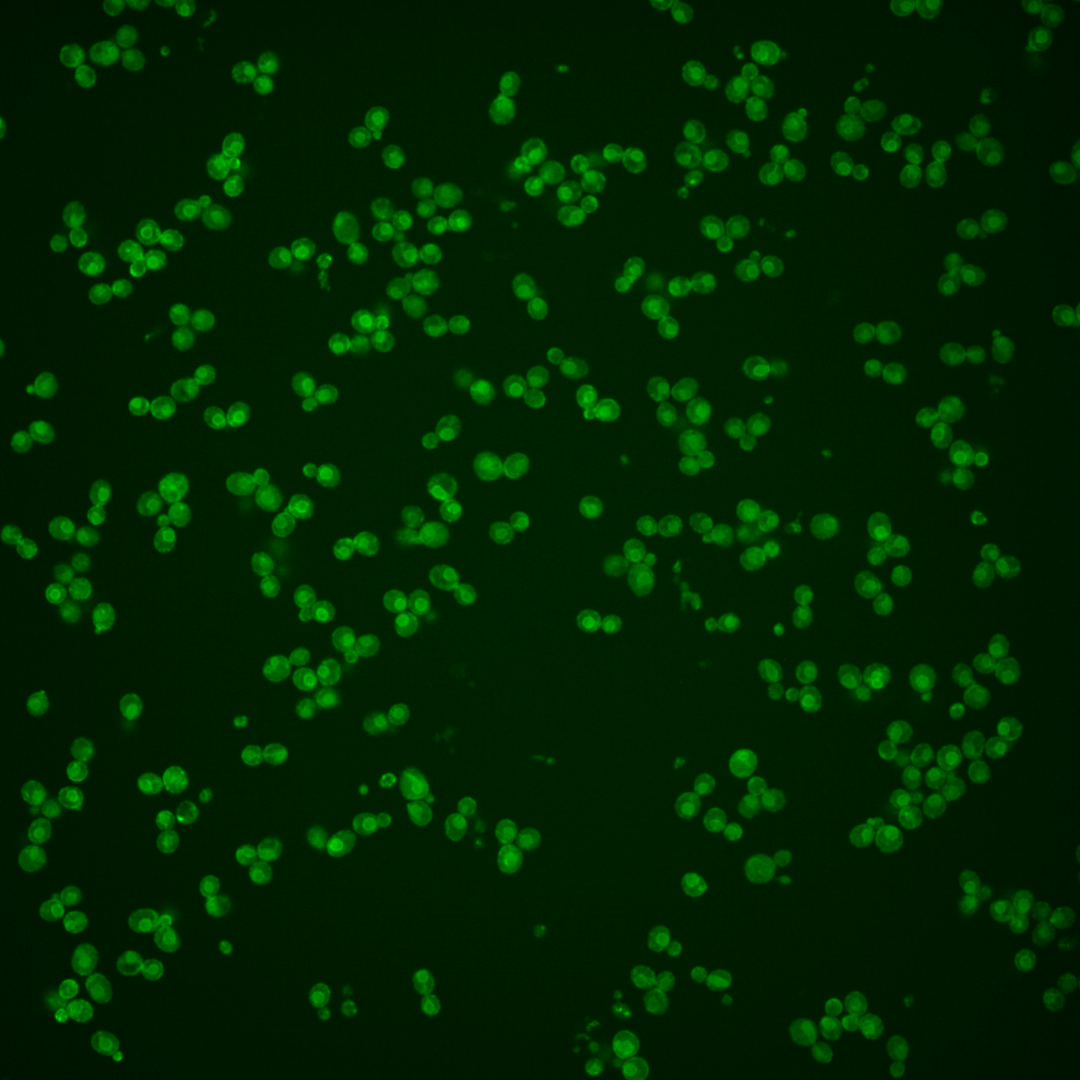
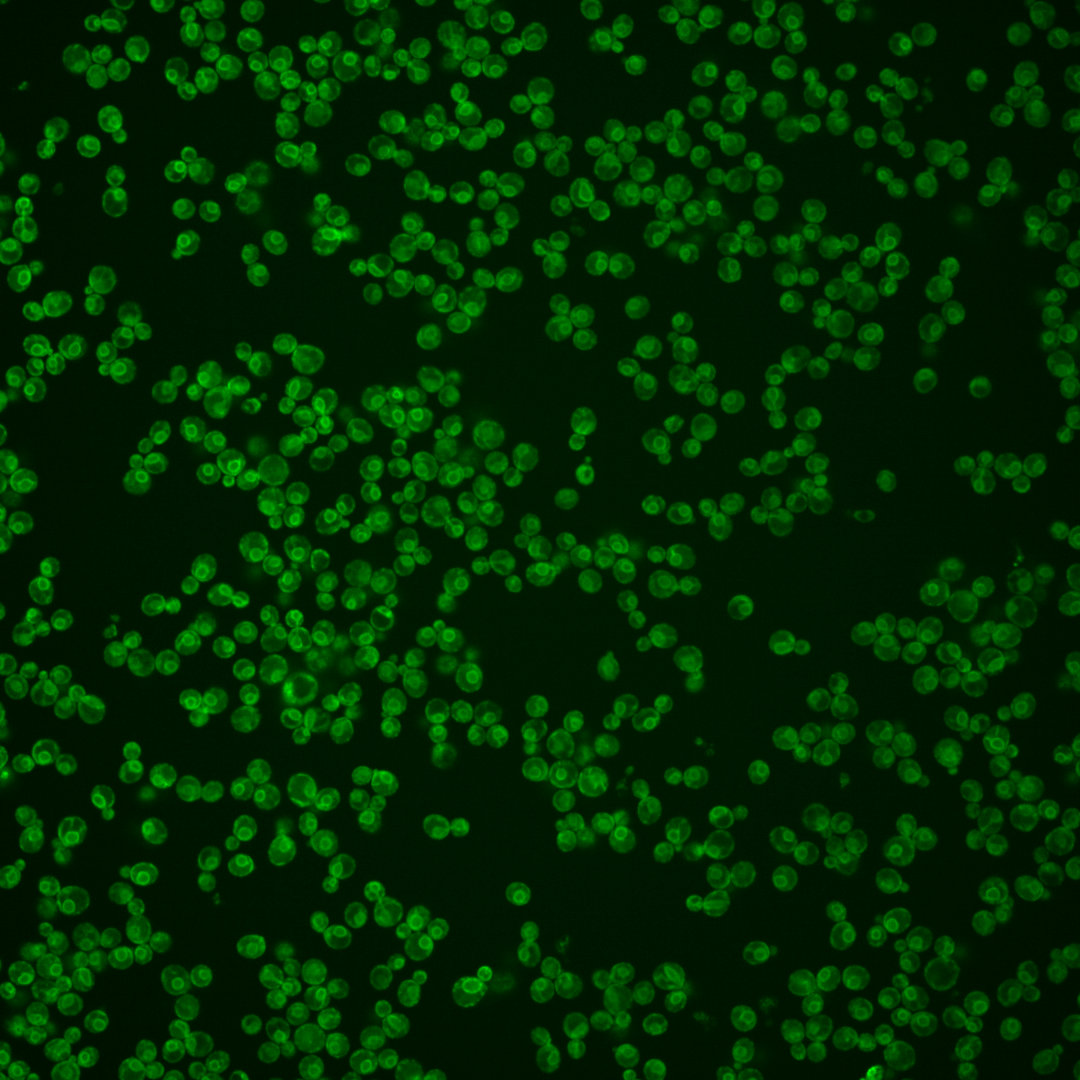
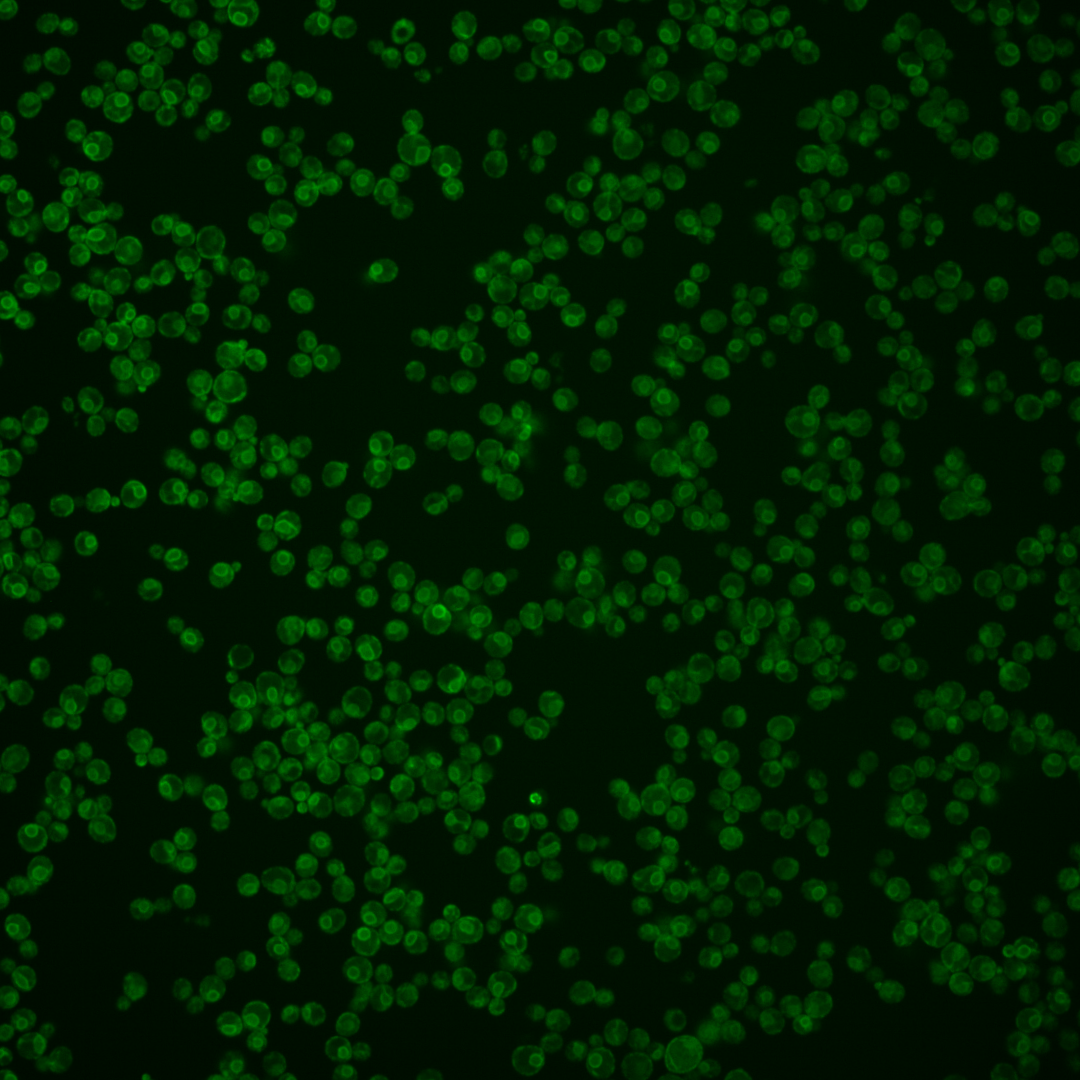

| Standard name | |
|---|---|
| Human Ortholog | |
| Description | Putative mannosidase; essential glycosylphosphatidylinositol (GPI)-anchored membrane protein required for cell wall biogenesis in bud formation, involved in filamentous growth, homologous to Dcw1p |
Micrographs




















































































Sub-cellular Localization
Yeast GFP Assignment
Protein Abundance
Localization Change
External localization resources
| ensLOC | DeepLoc | |||||||||||||||||||||||
|---|---|---|---|---|---|---|---|---|---|---|---|---|---|---|---|---|---|---|---|---|---|---|---|---|
| Localization | WT1 | WT2 | WT3 | RAP60 | RAP140 | RAP220 | RAP300 | RAP380 | RAP460 | RAP540 | RAP620 | RAP700 | HU80 | HU120 | HU160 | rpd3Δ_1 | rpd3Δ_2 | rpd3Δ_3 | WT1 | WT2 | WT3 | AF100 | AF140 | AF180 |
| Cortical Patches | 2 | 17 | 43 | 37 | 25 | 62 | 51 | 53 | – | 46 | 38 | 49 | 11 | 13 | 9 | 2 | 6 | 1 | 2 | 15 | 12 | 10 | 17 | 21 |
| Bud | 5 | 13 | 5 | 6 | 5 | 21 | 24 | 27 | – | 25 | 23 | 25 | 2 | 2 | 2 | 0 | 4 | 1 | 1 | 2 | 1 | 1 | 3 | 7 |
| Bud Neck | 0 | 0 | 0 | 0 | 0 | 0 | 0 | 0 | – | 0 | 0 | 0 | 0 | 0 | 0 | 0 | 0 | 0 | 1 | 7 | 3 | 4 | 7 | 11 |
| Bud Site | 0 | 0 | 0 | 0 | 0 | 0 | 0 | 0 | – | 0 | 0 | 1 | 0 | 0 | 0 | 0 | 0 | 0 | – | – | – | – | – | – |
| Cell Periphery | 15 | 22 | 60 | 41 | 37 | 58 | 47 | 46 | – | 39 | 31 | 48 | 65 | 65 | 81 | 5 | 13 | 2 | 2 | 6 | 8 | 21 | 58 | 91 |
| Cytoplasm | 12 | 81 | 37 | 28 | 52 | 77 | 129 | 179 | – | 178 | 164 | 189 | 48 | 48 | 55 | 7 | 32 | 11 | 4 | 17 | 3 | 13 | 8 | 13 |
| Endoplasmic Reticulum | 60 | 146 | 286 | 200 | 243 | 297 | 246 | 167 | – | 127 | 65 | 84 | 214 | 214 | 231 | 0 | 0 | 2 | 96 | 200 | 330 | 303 | 341 | 478 |
| Endosome | 0 | 0 | 1 | 0 | 0 | 1 | 4 | 9 | – | 4 | 7 | 2 | 0 | 0 | 0 | 0 | 0 | 0 | 0 | 1 | 1 | 1 | 0 | 0 |
| Golgi | 2 | 0 | 2 | 0 | 6 | 2 | 3 | 0 | – | 1 | 1 | 2 | 0 | 0 | 0 | 0 | 1 | 0 | 0 | 2 | 0 | 0 | 0 | 1 |
| Mitochondria | 0 | 2 | 1 | 3 | 2 | 2 | 0 | 1 | – | 5 | 2 | 1 | 0 | 0 | 0 | 1 | 2 | 1 | 1 | 1 | 2 | 3 | 4 | 4 |
| Nucleus | 0 | 0 | 0 | 0 | 0 | 0 | 0 | 0 | – | 0 | 0 | 2 | 2 | 2 | 2 | 1 | 2 | 0 | 0 | 0 | 0 | 0 | 0 | 0 |
| Nuclear Periphery | 0 | 0 | 0 | 1 | 1 | 3 | 1 | 2 | – | 2 | 1 | 0 | 0 | 0 | 0 | 0 | 0 | 0 | 0 | 0 | 0 | 0 | 0 | 1 |
| Nucleolus | 0 | 0 | 0 | 0 | 1 | 1 | 1 | 4 | – | 2 | 2 | 2 | 0 | 0 | 0 | 0 | 0 | 0 | 0 | 0 | 0 | 0 | 0 | 0 |
| Peroxisomes | 0 | 0 | 0 | 0 | 0 | 0 | 0 | 0 | – | 0 | 0 | 0 | 0 | 0 | 0 | 0 | 0 | 0 | 0 | 0 | 0 | 0 | 0 | 0 |
| SpindlePole | 0 | 0 | 0 | 0 | 0 | 0 | 1 | 0 | – | 1 | 0 | 0 | 0 | 0 | 0 | 1 | 1 | 0 | 0 | 0 | 0 | 0 | 0 | 0 |
| Vac/Vac Membrane | 3 | 2 | 0 | 4 | 12 | 4 | 14 | 14 | – | 15 | 16 | 10 | 1 | 1 | 6 | 3 | 5 | 1 | 2 | 4 | 0 | 8 | 7 | 14 |
| Unique Cell Count | 89 | 239 | 351 | 243 | 313 | 405 | 420 | 418 | 364 | 296 | 320 | 298 | 296 | 311 | 16 | 59 | 17 | 118 | 262 | 368 | 372 | 453 | 650 | |
| Labelled Cell Count | 99 | 283 | 435 | 320 | 384 | 528 | 521 | 502 | 445 | 350 | 415 | 343 | 345 | 386 | 20 | 66 | 19 | 118 | 262 | 368 | 372 | 453 | 650 | |
Yeast GFP Assignment
Protein Abundance
| Screen | WT1 | WT2 | WT3 | RAP60 | RAP140 | RAP220 | RAP300 | RAP380 | RAP460 | RAP540 | RAP620 | RAP700 | HU80 | HU120 | HU160 | rpd3Δ_1 | rpd3Δ_2 | rpd3Δ_3 | AF100 | AF140 | AF180 |
|---|---|---|---|---|---|---|---|---|---|---|---|---|---|---|---|---|---|---|---|---|---|
| Mean Cell GFP Intensity (1e-4) | 14.7 | 13.9 | 14.5 | 15.8 | 20.6 | 20.0 | 19.5 | 17.9 | – | 16.2 | 15.0 | 15.5 | 13.9 | 13.9 | 14.5 | 16.3 | 19.3 | 22.5 | 15.6 | 18.1 | 20.1 |
| Std Deviation (1e-4) | 2.9 | 2.9 | 2.8 | 3.0 | 4.1 | 4.1 | 3.5 | 3.5 | – | 3.6 | 3.0 | 2.9 | 2.0 | 2.0 | 2.1 | 4.7 | 7.0 | 8.3 | 2.6 | 3.5 | 4.2 |
| Intensity Change (Log2) | – | – | – | 0.13 | 0.51 | 0.47 | 0.43 | 0.31 | – | 0.16 | 0.05 | 0.1 | -0.06 | -0.06 | 0.0 | 0.18 | 0.42 | 0.63 | 0.11 | 0.32 | 0.48 |
Localization Change
| Localization | RAP60 | RAP140 | RAP220 | RAP300 | RAP380 | RAP460 | RAP540 | RAP620 | RAP700 | HU80 | HU120 | HU160 | rpd3Δ_1 | rpd3Δ_2 | rpd3Δ_3 |
|---|---|---|---|---|---|---|---|---|---|---|---|---|---|---|---|
| Cortical Patches | 1.0 | -1.8 | 1.2 | 0 | 0.2 | – | 0.2 | 0.2 | 1.2 | -3.9 | -3.5 | -4.5 | 0 | -0.5 | 0 |
| Bud | 0 | 0 | 2.8 | 3.1 | 3.5 | – | 3.6 | 4.0 | 4.0 | 0 | 0 | 0 | 0 | 0 | 0 |
| Bud Neck | 0 | 0 | 0 | 0 | 0 | – | 0 | 0 | 0 | 0 | 0 | 0 | 0 | 0 | 0 |
| Bud Site | 0 | 0 | 0 | 0 | 0 | – | 0 | 0 | 0 | 0 | 0 | 0 | 0 | 0 | 0 |
| Cell Periphery | -0.1 | -1.9 | -1.0 | -2.4 | -2.4 | – | -2.5 | -2.4 | -0.7 | 1.5 | 1.6 | 2.8 | 0 | 0.9 | 0 |
| Cytoplasm | 0.4 | 2.3 | 3.2 | 6.8 | 9.9 | – | 11.2 | 12.3 | 13.3 | 2.1 | 2.1 | 2.7 | 0 | 8.3 | 0 |
| Endoplasmic Reticulum | 0.3 | -1.2 | -2.7 | -6.8 | -11.7 | – | -12.6 | -15.1 | -14.4 | -2.9 | -2.8 | -2.2 | -7.7 | -12.6 | -6.8 |
| Endosome | 0 | 0 | 0 | 0 | 0 | – | 0 | 0 | 0 | 0 | 0 | 0 | 0 | 0 | 0 |
| Golgi | 0 | 0 | 0 | 0 | 0 | – | 0 | 0 | 0 | 0 | 0 | 0 | 0 | 0 | 0 |
| Mitochondria | 0 | 0 | 0 | 0 | 0 | – | 0 | 0 | 0 | 0 | 0 | 0 | 0 | 0 | 0 |
| Nucleus | 0 | 0 | 0 | 0 | 0 | – | 0 | 0 | 0 | 0 | 0 | 0 | 0 | 0 | 0 |
| Nuclear Periphery | 0 | 0 | 0 | 0 | 0 | – | 0 | 0 | 0 | 0 | 0 | 0 | 0 | 0 | 0 |
| Nucleolus | 0 | 0 | 0 | 0 | 0 | – | 0 | 0 | 0 | 0 | 0 | 0 | 0 | 0 | 0 |
| Peroxisomes | 0 | 0 | 0 | 0 | 0 | – | 0 | 0 | 0 | 0 | 0 | 0 | 0 | 0 | 0 |
| SpindlePole | 0 | 0 | 0 | 0 | 0 | – | 0 | 0 | 0 | 0 | 0 | 0 | 0 | 0 | 0 |
| Vacuole | 0 | 3.7 | 0 | 3.5 | 3.5 | – | 3.8 | 4.4 | 0 | 0 | 0 | 0 | 0 | 0 | 0 |
External localization resources
Images






























Protein Concentration and Protein Localization Data
| R1 | R2 | R3 | ||||||||||||||||
|---|---|---|---|---|---|---|---|---|---|---|---|---|---|---|---|---|---|---|
| G1 Pre-START | G1 Post-START | S/G2 | Metaphase | Anaphase | Telophase | G1 Pre-START | G1 Post-START | S/G2 | Metaphase | Anaphase | Telophase | G1 Pre-START | G1 Post-START | S/G2 | Metaphase | Anaphase | Telophase | |
| Concentration | 11.7536 | 13.2825 | 12.2676 | 13.8709 | 11.4248 | 12.8665 | 13.7343 | 16.3627 | 15.9572 | 16.4712 | 13.0755 | 14.855 | 15.3551 | 17.096 | 16.3344 | 16.2254 | 15.0805 | 15.6563 |
| Actin | 0.0484 | 0.0016 | 0.0431 | 0.0044 | 0.0458 | 0.0161 | 0.017 | 0.0001 | 0.0123 | 0.0005 | 0.0386 | 0.0008 | 0.0235 | 0.0001 | 0.0051 | 0.0012 | 0.0128 | 0.0005 |
| Bud | 0.0003 | 0.0026 | 0.0005 | 0.0003 | 0.0006 | 0.0002 | 0.0005 | 0 | 0.0001 | 0 | 0.0005 | 0 | 0.0001 | 0 | 0.0001 | 0 | 0.0002 | 0 |
| Bud Neck | 0.0013 | 0.0007 | 0.002 | 0.0005 | 0.0016 | 0.0017 | 0.0019 | 0.0001 | 0.0011 | 0.0002 | 0.0006 | 0.0005 | 0.0001 | 0.0001 | 0.0002 | 0.0001 | 0.0003 | 0.0002 |
| Bud Periphery | 0.0005 | 0.0017 | 0.0016 | 0.0017 | 0.0018 | 0.0006 | 0.0009 | 0.0005 | 0.0004 | 0.0001 | 0.0006 | 0.0002 | 0.0002 | 0.0001 | 0.0004 | 0.0001 | 0.0003 | 0 |
| Bud Site | 0.0017 | 0.0091 | 0.0035 | 0.0002 | 0.0014 | 0.0005 | 0.0076 | 0.0002 | 0.0008 | 0 | 0.0028 | 0.0001 | 0.0002 | 0.0001 | 0.0004 | 0 | 0.0023 | 0 |
| Cell Periphery | 0.0042 | 0.014 | 0.0118 | 0.0219 | 0.0142 | 0.0024 | 0.0044 | 0.0082 | 0.0102 | 0.0041 | 0.0008 | 0.0017 | 0.003 | 0.0145 | 0.0044 | 0.0204 | 0.002 | 0.001 |
| Cytoplasm | 0.064 | 0.0921 | 0.0884 | 0.0239 | 0.0353 | 0.0382 | 0.0068 | 0.0226 | 0.0157 | 0.0046 | 0.0094 | 0.0083 | 0.0127 | 0.0211 | 0.006 | 0.0083 | 0.0055 | 0.0088 |
| Cytoplasmic Foci | 0.0112 | 0.0013 | 0.0042 | 0.0005 | 0.0068 | 0.0026 | 0.0166 | 0.0003 | 0.0052 | 0.0006 | 0.033 | 0.0018 | 0.0047 | 0.0003 | 0.0014 | 0.0005 | 0.0116 | 0.0006 |
| Eisosomes | 0.0004 | 0.0001 | 0.0016 | 0.0001 | 0.0006 | 0.0001 | 0.0003 | 0 | 0.0001 | 0 | 0.0002 | 0.0001 | 0.0003 | 0 | 0.0002 | 0.0001 | 0.0003 | 0 |
| Endoplasmic Reticulum | 0.7534 | 0.833 | 0.7976 | 0.8767 | 0.7526 | 0.8779 | 0.8479 | 0.9553 | 0.9187 | 0.9754 | 0.7493 | 0.9536 | 0.913 | 0.9435 | 0.94 | 0.9562 | 0.8916 | 0.9726 |
| Endosome | 0.025 | 0.001 | 0.0044 | 0.0023 | 0.0262 | 0.0158 | 0.0229 | 0.0006 | 0.0068 | 0.005 | 0.0595 | 0.0053 | 0.0036 | 0.0002 | 0.0037 | 0.0013 | 0.0254 | 0.0043 |
| Golgi | 0.0094 | 0.0006 | 0.0036 | 0.0015 | 0.0158 | 0.0053 | 0.0122 | 0.0001 | 0.0084 | 0.0012 | 0.0191 | 0.0026 | 0.0054 | 0.0002 | 0.0025 | 0.0015 | 0.0145 | 0.0004 |
| Lipid Particles | 0.0225 | 0.0134 | 0.0105 | 0.0333 | 0.0243 | 0.0127 | 0.0203 | 0.0049 | 0.0064 | 0.0014 | 0.0263 | 0.0029 | 0.0131 | 0.0135 | 0.0032 | 0.0052 | 0.0066 | 0.0024 |
| Mitochondria | 0.0071 | 0.0001 | 0.0041 | 0.0002 | 0.0036 | 0.0029 | 0.008 | 0 | 0.0062 | 0.0001 | 0.0099 | 0.0135 | 0.0023 | 0 | 0.0241 | 0 | 0.006 | 0.0001 |
| None | 0.0034 | 0.0003 | 0.0027 | 0.0001 | 0.0066 | 0.0005 | 0.0013 | 0.0003 | 0.0001 | 0.0007 | 0.0017 | 0.0003 | 0.0006 | 0 | 0.0002 | 0.0001 | 0.0003 | 0.0002 |
| Nuclear Periphery | 0.0202 | 0.0132 | 0.0058 | 0.0051 | 0.0235 | 0.0108 | 0.008 | 0.0024 | 0.0028 | 0.0041 | 0.0062 | 0.0018 | 0.0048 | 0.0022 | 0.0036 | 0.0019 | 0.0025 | 0.0065 |
| Nucleolus | 0.0004 | 0.0002 | 0.0002 | 0 | 0.0014 | 0.0003 | 0.0006 | 0 | 0 | 0 | 0.0002 | 0.0001 | 0 | 0 | 0 | 0 | 0 | 0 |
| Nucleus | 0.0034 | 0.0089 | 0.0025 | 0.0005 | 0.0045 | 0.002 | 0.001 | 0.0002 | 0.0001 | 0.0001 | 0.0008 | 0.0003 | 0.0002 | 0.0001 | 0.0002 | 0.0001 | 0.0001 | 0.0004 |
| Peroxisomes | 0.0127 | 0 | 0.006 | 0 | 0.0017 | 0.0029 | 0.0113 | 0 | 0.001 | 0 | 0.0311 | 0.0005 | 0.0103 | 0 | 0.0003 | 0 | 0.0154 | 0 |
| Punctate Nuclear | 0.0047 | 0.0003 | 0.0022 | 0.0001 | 0.0222 | 0.0015 | 0.0013 | 0.0001 | 0.0001 | 0.0001 | 0.0039 | 0.0023 | 0.0002 | 0 | 0.0003 | 0 | 0.0005 | 0.0008 |
| Vacuole | 0.0048 | 0.0052 | 0.0032 | 0.0263 | 0.0082 | 0.0041 | 0.0058 | 0.004 | 0.0031 | 0.0015 | 0.0047 | 0.002 | 0.0012 | 0.004 | 0.0025 | 0.0028 | 0.0012 | 0.001 |
| Vacuole Periphery | 0.001 | 0.0005 | 0.0004 | 0.0003 | 0.0013 | 0.0008 | 0.0032 | 0.0001 | 0.0003 | 0.0002 | 0.0009 | 0.0014 | 0.0004 | 0 | 0.0011 | 0 | 0.0005 | 0.0002 |
Sequencing Data
| R1 | R2 | |||||||||
|---|---|---|---|---|---|---|---|---|---|---|
| G1 Post-START | S/G2 | Metaphase | Anaphase | Telophase | G1 Post-START | S/G2 | Metaphase | Anaphase | Telophase | |
| Gene Expression | 45.6747 | 44.412 | 27.6402 | 34.4835 | 58.6998 | 46.4503 | 52.3287 | 47.1726 | 39.1683 | 54.0615 |
| Translational Efficiency | 2.2679 | 1.7466 | 1.5696 | 1.3147 | 0.9541 | 1.7377 | 1.5159 | 1.0166 | 1.015 | 1.0586 |
Hit Data
| Dataset | Hit |
|---|---|
| Protein Concentration | ✘ |
| Protein Localization | ✘ |
| Gene Expression | ✘ |
| Translational Efficiency | ✘ |
Endocytosis
| Temp | Actin Patch (Sac6-tdTomato) | Cortical Patch (Sla1-GFP) | Late Endosome (Snf7-GFP) | Vacuole (Vph1-GFP) |
|---|---|---|---|---|
| 37℃ | ||||
| RT |
Cell Cycle Omics
CYCLoPs (Dfg5-GFP)
| Gene / Allele | Actin Patch (Sac6-tdTomato) | Cortical Patch (Sla1-GFP) | Late Endosome (Snf7-GFP) | Vacuole (Sac6-tdTomato) |
|---|
| Gene | Images |
|---|
| Gene | Images |
|---|
Images are not yet available
Images are not yet available